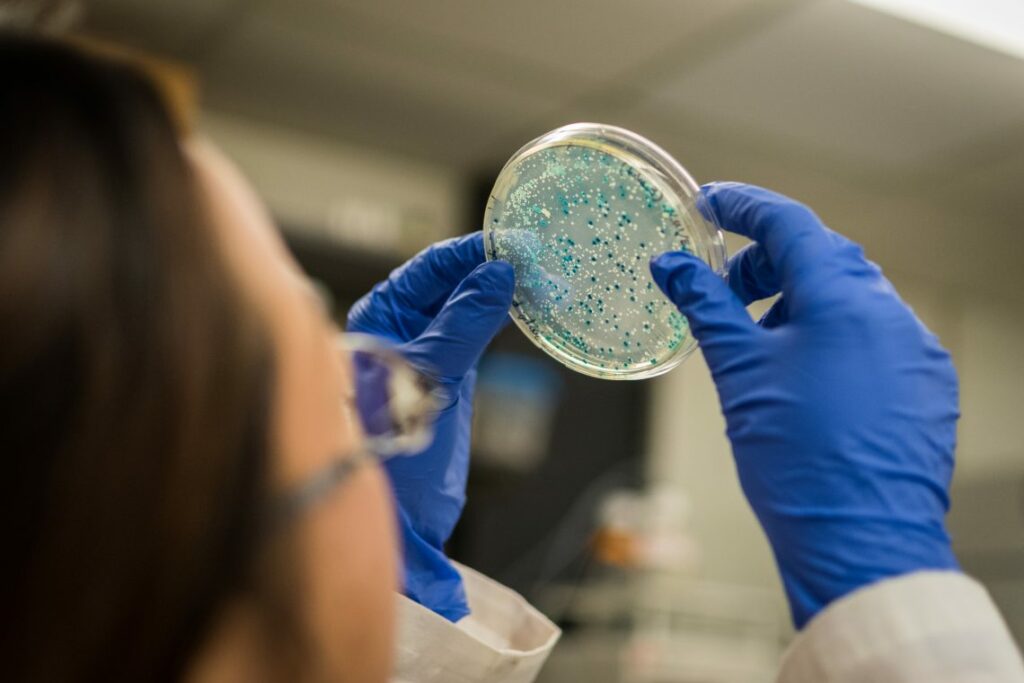
bacteria

North Dakota Warns Producers that Selling Seed into Canada has Risks

North Dakota warns producers selling seed to Canada of potential risks. Learn more about the potential risks and how to protect yourself.
Why we Need a Level Playing Field for All

Canada needs a level playing field for businesses to compete. Learn how the government is working to create a fair and competitive business environment for all.
BASF Crop Protection Innovation Pipeline with Projected Peak Sales Potential of €3.5 Billion

BASF’s crop protection innovation pipeline has a projected peak sales potential of €3.5 billion. Learn more about this breakthrough in crop protection technology.
What, How And Why Seed Businesses Should Use Copyrights

Start a seed business & protect your work with copyrights. Learn how to use copyrights to protect your seed business & ensure success.
Neonicotinoids: Risks To Bees Confirmed

Research confirms that neonicotinoids pose a risk to bees. Learn more about the effects of these pesticides and what can be done to protect bee populations.
A Close-up of the French Conseil d’Etat Request for a Preliminary Ruling of the ECJ on Mutagenesis

French Conseil d’Etat requests preliminary ruling from ECJ on mutagenesis: a legal analysis of the implications for the EU.
Be Dirt Rich – Part 2

Learn how to use dirt to create a rich, healthy garden. This article provides tips on soil preparation, composting, and more to help you get the most out of your garden.
Climate Change and Food Safety – Complete the EFSA Survey

Take part in the European Food Safety Authority’s survey on climate change and food safety. Learn how climate change affects food safety and how to protect yourself.
Scientists Monitor Crop Photosynthesis, Performance Using Invisible Light

Scientists use invisible light to monitor crop photosynthesis performance, improving crop yields and sustainability.
Starting from the Ground Up

Start your business off on the right foot with these tips for success. Learn how to create a business plan, find funding, and more.
The Secret to Tripling the Number of Grains in Sorghum

Learn how a secret project tripled the number of grains of sorghum, a drought-resistant crop, in the US. Find out how this could help farmers and the environment.
Separate Mutation from Modification: EU Farmers Need Plant Breeding Innovation More Than Ever

EU farmers need new plant breeding techniques to keep up with changing conditions. Learn how mutation and modification can help them adapt.
Is Agriculture Coming into a “Golden” Age?

Agriculture is entering a new era of innovation and technology. Learn how this golden age of farming is revolutionizing the industry and creating new opportunities.
Progress Made on Canadian Pulses in India

Progress made on Canadian pulses in India: Canada and India have made progress on resolving a trade dispute over Canadian pulses, with India agreeing to reduce tariffs and increase imports.
DowDuPont Ag Division to Become Corteva Agriscience

Corteva Agriscience is the new name for the DowDuPont Agriculture Division. Learn more about the new name and what it means for the future of the company.
VOLUME 5 ISSUE 1 – PLANT BREEDING INNOVATION – BRINGING SCIENCE BACK TO THE FOREFRONT

Learn about the latest developments in crop protection from Volume 5, Issue 1 of the European Crop Protection Magazine. Read about the latest research and industry news.
EFSA’s Advisory Forum Calls for More Public Investment in Food Safety Research

Public investment in food safety research is essential, according to the European Food Safety Authority’s Advisory Forum. Learn more about their call for action.
DowDuPont Agriculture Division To Become Corteva Agriscience

DowDuPont’s agriculture division is rebranding as Corteva Agriscience. Learn more about the new name and what it means for the future of the company.
Nippon Soda and Syngenta Enter into Global Licensing Agreement for Novel Seed Treatment Technology

Nippon Soda and Syngenta enter global licensing agreement to develop and market seed treatment products. A new era of innovation in crop protection begins.
Finding the Right Fit

Find the perfect job for you with these tips on researching companies, networking, and more. Get the job you want today!
Status Britain: A Revolution Needed for Growers to Capitalize on Brexit

Brexit is a major opportunity for British farmers, but they need a revolution in status and capital to capitalize on it. Learn how to make the most of Brexit in this article.
Status Canada: Seed Synergy Website Launches

Status Canada Seed Synergy website launches! Learn about the new website and how it will help Canadian farmers access the latest seed technology.
Want to Know About Technological Disruption? Listen to our Latest Webinar!
Technology is changing the way we live and work. Learn how to stay ahead of the curve and prepare for the future of technological disruption.
Hooked on Agriculture

Learn how the agricultural industry is using technology to increase efficiency and sustainability. Discover the benefits of hooked agriculture and how it is revolutionizing the industry.
Scientists Create ‘Evolutionwatch’ for Plants

Scientists create EvolutionWatch to track plant evolution in real-time. Monitor changes in plants over time to better understand how they adapt to their environment.
Status EU: CPVO and ARIPO Sign Administrative Agreement

EU and ARIPO sign agreement to facilitate the protection of plant varieties. Cooperation to ensure efficient and effective protection of plant varieties in both regions.
How Bacteria Manipulate Plants
Bacteria can manipulate plants to their advantage. Learn how in this article, which explores the fascinating relationship between bacteria and plants.
From Hogs to Vegetables

Learn how to raise hogs and grow vegetables in your own backyard. Get tips on the best practices for raising hogs and growing vegetables for a successful homestead.
Rest Assured, CSAAC Will Only Get Stronger

CSAAC is a Canadian organization that is dedicated to helping those with disabilities. Learn how CSAAC is working to become stronger and how you can help.
Status India: NSAI Unhappy with Decision to Compensate Farmers Following Pink Bollworm Loss

India’s NSai unhappy with decision to compensate farmers for pink bollworm losses. Learn why and what the government is doing to help.
Dow and DuPont Join Superclusters Initiative

Dow and DuPont join forces to become part of Canada’s Superclusters Initiative, a program to drive innovation and economic growth.
The EU Grain Trade Weighs in on the Plant Breeding Innovation Debate

EU grain trade debates the impact of plant breeding innovation on food security, sustainability, and the environment.
Scientists Poised to Win the Race Against Rust Disease and Beyond

Scientists are close to winning the race against rust disease, a major threat to crops. Learn how they are using new technology to combat it.
Status Israel: ADAMA and ALRISE Biosystems Collaborate on R&D

Israel-based Adama and US-based Alrise Biosystems collaborate on R&D to develop innovative crop protection solutions.
Increased Investment in Golden Harvest Seeds Results in More Robust Portfolio for Farmers

Golden Harvest Seeds invests in farmers with a robust portfolio of products, resulting in increased yields and better quality crops.
Scientists Confirm Value of Whole Grains and Wheat for Nutrition and Health

Whole grains are essential for good health! Scientists confirm the nutritional value of wheat and other grains, outlining their benefits for a healthy diet.